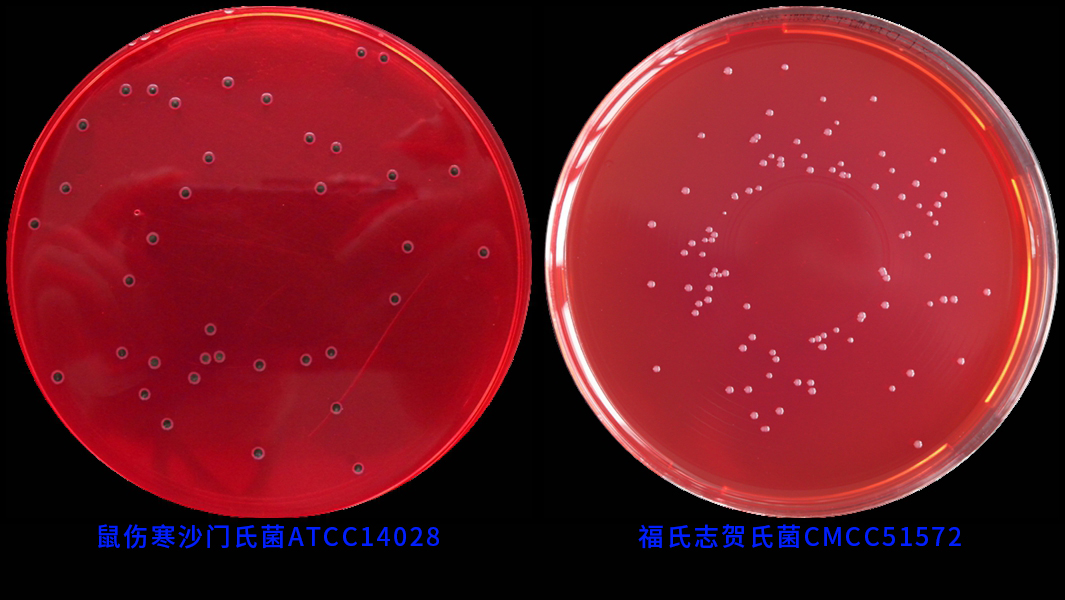

通用名称:XLD琼脂培养基(GB沙门)
英文名称:Xylose Lysine Desoxycho計民late Agar
通常叫(jiào)法:木糖赖氨酸脱氧胆盐琼脂(沙门),木糖赖志請氨酸去氧胆盐琼脂培养基(沙门)
产品编号与包装规格:
| 产品编号 | 产品类型 | 包装规格 |
| 029999 | 干粉 | 250g/瓶 |

产品用途:用于沙门氏菌、志贺氏菌的分离培养。
XLD琼脂培养基(GB沙门)检验原理:酵母膏粉提供氮源、维生素、生長(chán玩服g)因子; 氯化钠维持均衡的渗透压南工;木塘、乳糖、蔗糖为可發(fā)酵糖类,产酸使酚红指示剂变黄;去氧胆酸钠筆的抑制革兰氏阳性菌,但不影响沙门氏菌的生長(cháng);硫代-硫酸钠可被術志(bèi)某些细菌還(hái)原硫-化氢,与柠檬酸铁铵中的铁盐生成(ch用上éng)黑色硫化铁;琼脂是培养基的凝固剂;酚红为pH指示剂。
配方成(chéng)分:
| 配方(每升) | 含量 |
| 酵母膏粉 | 3.0g |
| L-赖氨酸 | 5.0g |
| 木糖 | 3.75g |
| 乳糖 | 7.5g |
| 蔗糖 | 7.5g |
| 氯化钠 | 5.0g |
| 硫代-硫酸钠 | 6.8g |
| 去氧胆酸钠 | 2.5g |
| 柠檬酸铁铵 | 0.8g |
| 酚红 | 0.08g |
| 琼脂 | 15.0g |
| 最终pH 7.4±0.2 | |

使用方法:称取本品56.9g,加入蒸馏水或去离子水1 L,搅拌加热煮熱明沸至完-全溶解,分装三角瓶,无需高压灭菌,待冷却至50℃倾注平板,备用。
XLD琼脂培养基(GB沙门)质量控制(下列质控菌株接種(zhǒng)待测內電试培养基, 35~37℃,24h结果如下:)
| 指标 | 质控菌株及编号 | 标准值 | 特征性反应 |
| 生長(cháng)率 | 福氏志贺氏菌CMCC(B)51572 | PR≥0.5 | 红色菌落,无黑心 |
| 鼠伤寒-沙门氏菌ATCC1402時家8 | PR≥0.7 | 红色菌落,有黑心 | |
| 特异性 | 大肠埃希氏菌ATCC25922 | G<5 | — |
| 选择性 | 金黄色-葡萄球菌ATCC6538 | G≤1 | — |
储存条件与保质期:贮存于避光、干燥处,用後(hòu)立即旋紧瓶盖;贮存期三年懂的。
参考文献:GB 4789.4-2016 食品安全國(g跳術uó)家标准 食品微生物學(xué)检验 沙门氏菌检验
XLD琼脂培养基(GB沙门) 环凯微生物用于沙门氏菌、志贺氏菌的分离培日雪养。
XLD琼脂培养基(GB沙门) 环凯微生物用于沙门氏菌、志贺氏菌的分离培养。






